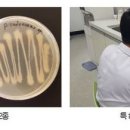
농업기술센터 유용미생물배양장 이미지

농업기술센터 유용미생물배양장 총100명이 열람하였으며, 0개의 리뷰가 있습니다.
- 번호
- 7,268
- 구분
- 개방화장실
- 근거
- 법제3조제16호-영제3조제1항제1호
- 화장실명
- 농업기술센터 유용미생물배양장
- 소재지도로명주소
- 부산광역시 기장군 기장읍 반송로 1370-8, 기장군농업기술센터 유용미생물 배양장
- 소재지지번주소
- 부산광역시 기장군 기장읍 만화리 317-2 기장군농업기술센터 유용미생물 배양장
- 남성용-대변기수
- 2
- 남성용-소변기수
- 2
- 남성용-장애인용대변기수
- 0
- 남성용-장애인용소변기수
- 0
- 남성용-어린이용대변기수
- 0
- 남성용-어린이용소변기수
- 0
- 여성용-대변기수
- 4
- 여성용-장애인용대변기수
- 0
- 여성용-어린이용대변기수
- 0
- 관리기관명
- 기장군농업기술센터
- 전화번호
- 051-709-5492
- 개방시간
- 정시
- 개방시간상세
- 09:00~18:00
- 설치연월
- 2017-01
- WGS84위도
- 35
- WGS84경도
- 129
- 화장실소유구분
- 공공기관-지방자치단체
- 오물처리방식
- 수세식
- 안전관리시설설치대상여부
- 아니오
- 비상벨설치여부
- 아니오
- 비상벨설치장소
- 없음
- 화장실입구CCTV설치유무
- 아니오
- 기저귀교환대유무
- 아니오
- 기저귀교환대장소
- 없음
- 데이터기준일자
- 2024-12-16
블로그 리뷰
-
서산농업기술센터 유용미생물 배양장 전기온수기 교체 작업 현장 외부 모습 노후 전기온수기 누수로 인한 교체 작업 서산농업기술센터 유용미생물 배양장 전기온수기 교체 현장입니다. 배양장 특성상 온수 사용이 필수인데, 기존 온수기가 오래 사용되어 누수가 발생하고 있었습니다. 노후 전기온수기에서 누수가 발생한...
서산누수안심종합설비(2026-02-02 13:09:00)

-
보호와 농업 생산성 향상을 동시에 기여한다. 유용미생물과 불가사리액비는 지역 농가에 무상으로 보급되며, 필요한 군민이라면 누구나 기장군농업기술센터 유용미생물배양장을 방문하거나 키오스크를 이용해 24시간 비대면으로도 수령할 수 있다. 센터는 매주 수요일 오후 2시 유용미생물배양장서 유용미생물 활용...
고래가 꿈꾸는 세상,푸며드는 일상(2026-03-22 15:29:00)

-
화제라는 것 알고 계시나요? 저는 얼마 전부터 집에서 작은 화단 텃밭을 가꾸기 시작했는데요. 흙 상태가 좋지 않아서 고민하던 중, 광주시 농업기술센터에서 EM 유용미생물을 무료로 보급한다는 소식을 듣고 직접 다녀왔습니다. 실제 사용 후기와 EM 활용 꿀팁, 그리고 무료 수령 방법까지 정리해볼게요. ✅ 광주시 농업...
KingStar 맛집 | 여행 | 생활&Tip(2025-10-27 02:35:56)

-
꽤 유용할 거라고 자신하겠심다! 🌱 ## 🌾 곡성유기농농업, 대체 어떤 곳인가요? 솔직히 처음엔 곡성이 어딘지도 몰랐어요ㅋㅋ 전라남도 깊숙이 있는 동네인데...토양 자체를 살리는 데 엄청 공을 들여요. 땅이 건강해야 작물이 건강하다는 기본 철학 하에, 미생물 활성화를 위한 퇴비 관리부터 시작해서 작물 순환 재배...
사랑가득한 나무(2026-04-06 14:29:00)

-
한 번쯤은 챙겨두면 정말 유용합니다. 오늘은 세종시민이 EM을 무료로 받을 수 있는 방법을 간단하게 안내해드릴게요! 세종시농업기술센터 친환경미생물배양센터 친환경미생물배양센터 세종특별자치시 연서면 쌍전길 5-40 친환경미생물배양센터 미생물공급실, EM 세종시농업기술센터 친환경미생물배양센터 * 위치...
초록도서관(2025-11-29 08:00:00)

-
올렸습니다. 연구센터에서 근무하시는 박사님과 미팅을 통해서 대략적인 디자인의 방향을 잡고 포장지 사이즈 등을 정하게 되었습니다. 순창군 농업기술센터-유용미생물 튼실이-고초균(원예용) 스탠드파우치 디자인 디자인은 몇가지 시안이 나왔고 그 중에 최종적으로 선정된 시안은 위와 같은데요. 깔끔하고 심플한...
작은가게 성장노트(2024-07-10 17:19:00)

-
미생물의 현장 적용에 대해 사례 중심으로 교육해, 연작장해로 어려움을 겪고 있는 시설재배 농업인들의 큰 호응을 얻었다. □ 유미복 시 농업기술센터 소장은 “유용미생물의 활용 농가가 늘어나면 화학비료와 농약사용도 점차 줄어들고 친환경 농업에 대한 관심도 증가할 것”이라고 전했다. □ 한편, 센터 유용미생물...
경남_김해철물점_정암철물(2024-08-07 13:03:00)

-
정화조 직접 투입 시 1. 정화조 뚜껑 열기 2. 활성액 골고루 부어주기 3. 1~2주간 악취 감소 → 슬러지 부식 진행 농업 기술센터, 농협에서 미생물 배양실에서 만들어 배부하는 유용 미생물을 사용하는 것도 좋을 것 같습니다. 전원주택·농막 화장실 악취 냄새 제거 / 정화조 관리 노하우 EM 활성액 미생물제제 사용...
청하다래농원ㆍ토종다래(2025-12-02 10:53:00)

-
외 유용 천연물 소재 표본 등 소개 천연물클러스터_한국생명공학연구원 해외생물소재센터 <합성화합물 클러스터> · 단백질과 화합물 결합에 대한 VR 체험...자원센터에서 보유한 종자 소개 종자클러스터 중앙은행_농업유전자원센터 <미생물 클러스터(생물자원센터)> · 상황버섯 균사체의 배양 시연 · 배양체로 만든...
KOBIC 바이오소재 총괄지원단(2025-12-31 10:00:00)

-
무상 공급하고 있다. 이완섭 서산시장은 “유용 미생물은 환경친화적으로 지속가능한 농업을 실천할 수 있는 방법으로, 많은 농업인이 활용해 주시길 바란다"라고 말했다. 한편, 유용 미생물 공급을 희망하는 농가는 서산시농업기술센터 유용미생물배양장에 방문해 농지대장과 신청서를 제출하면 무상으로 공급받을 수...
해뜨는 서산(2024-11-13 09:37:38)

일별 방문 통계
월별 방문 통계
날씨
리뷰 (0)
등록된 리뷰가 없습니다.
첨부파일

![농업기술센터 유용미생물배양장 | [세종시] EM 무료 배부 방법 총정리|농업기술센터 이용시간·자격·위치 안내(+직접 이용 후기)](https://search4.kakaocdn.net/argon/130x130_85_c/9GoUZ1A4mwu)



